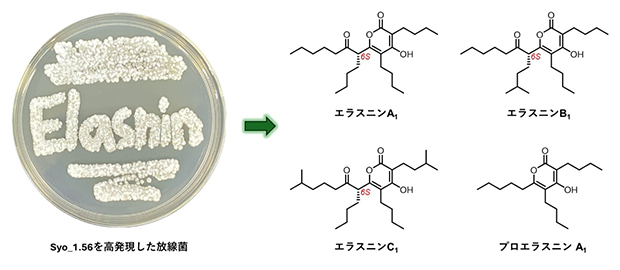
新規エラスニン誘導体の構造および生物活性の図

理化学研究所(理研)環境資源科学研究センター 天然物生合成研究ユニットの高橋 俊二 ユニットリーダー、イスラム・アデル・アブデルハキム・アミン 基礎科学特別研究員らの共同研究グループは、放線菌[1]Streptomyces sp. RK18-A0406を用いて強い抗菌活性を有する新規のエラスニン[2]誘導体を単離しました。
今回、共同研究グループは、これまで解析されていなかったSARPファミリー転写制御因子[3](Syo_1.56)をStreptomyces sp. RK18-A0406で高発現させることによって、二次代謝物の生産を誘導し、既知のアンチマイシン類、12種類のエラスニン誘導体(10種類は新規化合物)の高生産と構造決定に成功しました。また、エラスニンの絶対立体配置[4]は6Sと決定しました。さらに、Syo_1.56は、近傍に存在する生合成遺伝子クラスター(BGC)[5]の発現を特異的に活性化するのではなく、離れた位置に存在する二つの異なるBGCの発現を誘導することを明らかにしました。取得した天然化合物の生物活性を評価したところ、すべてのエラスニンは野生型の黄色ブドウ球菌に対して強い抗菌活性を、エラスニン誘導体のいくつかは抗マラリア活性およびメタロ-β-ラクタマーゼ(MBL)[6]阻害活性をそれぞれ有していました。
本研究成果から、転写制御因子の発現を人為的に誘導し、放線菌で休眠しているBGCを活性化することで、新規の抗菌化合物を開発できると期待されます。
本研究は、科学雑誌『Journal of Natural Products』オンライン版(4月23日付)に掲載されました。
新規エラスニン誘導体の構造および生物活性
背景
放線菌は、多様な構造と活性を有する二次代謝産物を生産します。近年、大規模な微生物ゲノム配列の解読とバイオインフォマティクス解析により、多くのBGCが見いだされています。しかし、実験室の培養条件ではほとんどの遺伝子は休眠しており、放線菌が有している新規天然物の生産能力を十分に引き出すことができていません。休眠BGCの活性化は、ユニークな化学構造、生物活性、作用機序を持つ新規二次代謝産物を取得する有望なアプローチとなります。
本研究では、未解析であったSARPファミリー転写制御因子に着目し、遺伝子発現を活性化して新規の天然化合物の生産誘導を検討しました。
研究手法と成果
SARPファミリー転写制御因子であるFur22注)のアミノ酸配列情報を使用し、共同研究グループで保有する放線菌ゲノム配列データベースから類似の配列を探索しました。その結果、Streptomyces sp. RK18-A0406のゲノム配列から、未知のⅡ型ポリケチド合成酵素[7]遺伝子クラスター近傍に機能が未解明の転写制御因子(Syo_1.56)を見いだしました。次に、アプラマイシン耐性遺伝子を含む組み込み型ベクター(運び屋)を用いて、発現プロモーター下流にsyo_1.56遺伝子をクローン化しました。放線菌Streptomyces sp. RK18-A0406に上記のベクターを導入し、得られた形質転換株の培養抽出液を超高速液体クロマトグラフ質量分析装置(UHPLC-MS)[8]で分析したところ、野生株の培養物からは検出されない複数の代謝物のピークが確認されました(図1)。
生産された二次代謝産物のピークは、吸収スペクトル、高分解能質量分析、および核磁気共鳴(NMR)解析から、既知のアンチマイシンおよび新規エラスニン誘導体と予想されました。実際に、形質転換株の大量培養・精製を行った結果、12種類のエラスニン誘導体(10種類は新規化合物)の単離と構造決定に成功しました(図1)。また、syo_1.56遺伝子はⅡ型ポリケチド合成酵素遺伝子クラスターの近傍に位置していましたが、予想に反して、候補の二次代謝産物は形質転換株の培養液から検出できませんでした。アンチマイシンとエラスニンの生合成に関わる二つのBGCを活性化することから、Syo_1.56はこれまでに知られている経路特異的な制御因子ではなく、多面的な制御因子としての性質を持つことが示唆されました。

図1 Streptomyces sp. RK18-A0406の代謝産物の解析
5日間菌体を培養後、代謝産物を抽出し、UHPLC-MS解析を行った。転写制御因子の導入株は、野生株からは検出できなかったアンチマイシン(赤ピーク)およびエラスニン(青ピーク)類の生産を強く誘導した。
分子量(MW)に基づいて、単離されたエラスニン誘導体はエラスニンA(MW392)、エラスニンB(MW406)、エラスニンC(MW420)、およびプロエラスニン(MW<392)に分類されました。エラスニンの絶対立体配置は、6Sと決定されました。単離されたエラスニンは全て、野生型黄色ブドウ球菌に対して強力な抗菌活性を示し、IC50値(50%阻害濃度)[9]は0.5~2.6μg/mLの範囲でした。また、メチシリン耐性黄色ブドウ球菌(MRSA)[10]株に対する抗菌活性を調べたところ、プロエラスニンは7.5~30μg/mLの範囲の最小発育阻止濃度(MIC)値を示しました。エラスニン誘導体のMRSAに対する活性は分子量と相関しており、エラスニンCが最も強力であり、MIC値は2.5~6.0μg/mLの範囲であることが分かりました。
エラスニン誘導体の一部は、マラリア原虫(Plasmodium falciparum 3D7株)に対して中程度から強力な抗マラリア活性を示しました(IC50値は0.1~9.4µg/mL)。ヒト細胞株(HeLaおよびHL-60)に対しては顕著な細胞毒性を示さないことから、抗マラリア薬としての開発の可能性が示唆されました。
抗生物質耐性を引き起こすことが知られているメタロ-β-ラクタマーゼ(MBL)の活性阻害効果を試験管内(in vitro)で検討しました。興味深いことに、ポジティブコントロールであるカプトプリルIC50値69マイクロモーラー(μM、M(モーラー)はmol/L(モル毎リットル)で、1μMは100万分の1モーラー)と比較して、エラスニンA1、エラスニンB3、およびエラスニンC1に対するIC50値はそれぞれ24.1、10.8、および15.3μMと強い活性を示し、エラスニンが抗菌薬の開発に向けて良いリード化合物であることが示唆されました。プロエラスニンはMBL阻害活性を示さないことから、C6に結合したアシル鎖がMBL阻害に重要であることが示唆されました。
- 注)Panthee S., et al. Furaquinocins I and J: Novel polyketide isoprenoid hybrid compounds from Streptomyces reveromyceticus SN-593. J. Antibiot., 64(7), 509-513 (2011)
今後の期待
放線菌においてBGCを一括制御する経路特異的転写制御因子とは異なり、Syo_1.56はゲノム上で全く異なる位置に存在する二つのBGCを活性化することが判明しました。放線菌でこのような経路非特異的転写制御因子の例は少なく、このような転写制御因子を活用することによって、休眠BGCを覚醒させ、多様な構造とユニークな生物活性を有する新規の天然化合物を取得できることが期待されます。
また、野生株およびメチシリン耐性黄色ブドウ球菌に対するエラスニン誘導体の構造活性相関、抗マラリア活性、MBLの活性阻害効果の研究は、将来の創薬の開発につながることが期待されます。
本研究成果は、国際連合が定めた17項目の「持続可能な開発目標(SDGs)[11]」のうち、「3.すべての人に健康と福祉を」に貢献するものです。
補足説明
- 1.放線菌
土壌中など自然界に広く存在する真正細菌であり、複雑な構造を持つ二次代謝産物を生産する。人類は、それらの中から、医薬、農薬、動物薬などの生理活性を持つ物質を利用してきた。現在も医薬探索源として重要視されている。 - 2.エラスニン
1978年に大村智博士(2015年ノーベル生理学・医学賞受賞)によってヒト顆粒球エラスターゼ阻害活性を有するポリケチド化合物として単離された。 - 3.SARPファミリー転写制御因子
SARPファミリーに属する転写制御因子。主にStreptomyces属放線菌の二次代謝生合成遺伝子クラスター内に存在し、経路特異的な転写制御因子として知られている。抗菌剤、抗真菌剤、抗腫瘍剤など、さまざまな二次代謝物生産に関わる生合成遺伝子クラスターを制御する上で重要な役割を果たす。SARPはStreptomyces antibiotic regulatory proteinの略。 - 4.絶対立体配置
化合物の立体的な構造のこと。化合物の立体異性体は原子の数と種類は同じでも、その空間的な配置が異なる場合には、重ね合わせることができない。この空間的な配置のことを絶対配置といい、RとS、EとZなどと表記し分類が可能である。化合物の絶対立体配置が異なる場合は、生理活性が異なる可能性があるため、その解明は重要である。 - 5.生合成遺伝子クラスター(BGC)
放線菌や糸状菌などの微生物二次代謝産物の生合成では、関連する全ての遺伝子がゲノム上に近接して存在し、クラスターを形成する。転写制御因子などにより、これらの遺伝子は協調的に制御され、効率よく二次代謝産物が生産される。多くの遺伝子クラスターは休眠しており有効活用が期待されている。 - 6.メタロ-β-ラクタマーゼ(MBL)
カルバペネムを含む広範囲のβ-ラクタム系抗生物質の加水分解を触媒する酵素。活性中心に亜鉛を有する。MBLを阻害することは抗生物質の効果を回復させる方法の一つ。 - 7.ポリケチド合成酵素
主に細菌、菌類、植物に見られ、ポリケチド(polyketide)化合物を生合成する酵素。Ⅰ、Ⅱ、Ⅲ型の3種が存在する。ポリケチド化合物の一部は、実際に抗生物質、抗がん剤、免疫抑制剤などの医薬品として利用されている。 - 8.超高速液体クロマトグラフ質量分析装置(UHPLC-MS)
高速液体クロマトグラフィー(HPLC)の分離能、速度、感度を大幅に向上させた解析装置であるUHPLCユニットに、質量分析装置(MS)が組み合わされている。UHPLCユニットでは化学的特性の違い、MSユニットでは質量の違いを基に化合物を分離できる。そのため、複雑な混合物の中から目的化合物を素早く解析することが可能。UHPLC-MSはultra-high performance liquid chromatography - mass spectrometryの略。 - 9.IC50値(50%阻害濃度)
細菌や細胞などの生育を50%に阻害する薬物の濃度。この値が小さいほど強い効果を持つことを示す。 - 10.メチシリン耐性黄色ブドウ球菌(MRSA)
抗生物質であるメチシリンに耐性を獲得した黄色ブドウ球菌。抗生物質に耐性を持ち、感染症治療が困難であることから、医療現場で問題となっている。MRSAはmethicillin-resistant Staphylococcus aureusの略。 - 11.持続可能な開発目標(SDGs)
2015年9月の国連サミットで加盟国の全会一致で採択された「持続可能な開発のための2030アジェンダ」にて記載された、2016年から2030年までの15年間で達成する国際目標。持続可能な世界を実現するための17のゴール、169のターゲットから構成され、発展途上国のみならず、先進国自身が取り組むユニバーサル(普遍的)なものであり、日本としても積極的に取り組んでいる(外務省ホームページから一部改変して転載)。SDGsはSustainable Development Goalsの略。
共同研究グループ
理化学研究所 環境資源科学研究センター
天然物生合成研究ユニット
ユニットリーダー 高橋 俊二(タカハシ・シュンジ)
基礎科学特別研究員 イスラム アデル アブデルハキム アミン(Islam Adel Abdelhakim Amin)
特別研究員(研究当時)鬼頭 奈央子(キトウ・ナオコ)
植物免疫研究グループ
グループディレクター 白須 賢(シラス・ケン)
研究員 増田 幸子(マスダ・サチコ)
テクニカルスタッフⅡ 柴田 ありさ(シバタ・アリサ)
分子構造解析ユニット
ユニットリーダー 越野 広雪(コシノ・ヒロユキ)
専任研究員 村中 厚哉(ムラナカ・アツヤ)
化合物リソース開発研究ユニット
ユニットリーダー 長田 裕之(オサダ・ヒロユキ)
上級研究員 二村 友史(フタムラ・ユウシ)
北里大学大村智記念研究所
教授 浅見 行弘(アサミ・ヒロユキ)
(理研 環境資源科学研究センター 天然物生合成研究ユニット 客員研究員)
教授 花木 秀明(ハナキ・ヒデアキ)
国立感染症研究所 品質保証・管理部
主任研究官 石川 淳(イシカワ・ジュン)
研究支援
本研究は、日本学術振興会(JSPS)科学研究費助成事業基盤研究(A)「天然化合物の多様性拡張を志向した生合成分子基盤の解明(研究代表者:高橋俊二)」、同学術変革領域研究(A)「AIを活用した未知の二次代謝生合成酵素の機能解明と分子間相互作用の精密解析(研究代表者:高橋俊二)」による助成を受けて行われました。抗菌活性およびメタロ-β-ラクタマーゼ活性試験の一部は、日本医療研究開発機構(AMED)創薬等ライフサイエンス研究支援基盤事業 創薬等先端技術支援基盤プラットフォーム(BINDS)の「大村天然化合物ライブラリーの拡充と創薬研究ネットワークを基盤としたリード創出(JP22ama121035)」の支援を受けて行われました。
原論文情報
- Islam A. Abdelhakim, Yushi Futamura, Yukihiro Asami, Hideaki Hanaki, Naoko Kito, Sachiko Masuda, Arisa Shibata, Atsuya Muranaka, Hiroyuki Koshino, Ken Shirasu, Hiroyuki Osada, Jun Ishikawa, and Shunji Takahashi, "Expression of Syo_1.56 SARP Regulator Unveils Potent Elasnin Derivatives with Antibacterial Activity", Journal of Natural Products, 10.1021/acs.jnatprod.4c00259
発表者
理化学研究所
環境資源科学研究センター 天然物生合成研究ユニット
ユニットリーダー 高橋 俊二(タカハシ・シュンジ)
基礎科学特別研究員 イスラム アデル アブデルハキム アミン(Islam Adel Abdelhakim Amin)
 イスラム・アミン(左)、高橋 俊二(右)
イスラム・アミン(左)、高橋 俊二(右)
報道担当
理化学研究所 広報室 報道担当
お問い合わせフォーム
